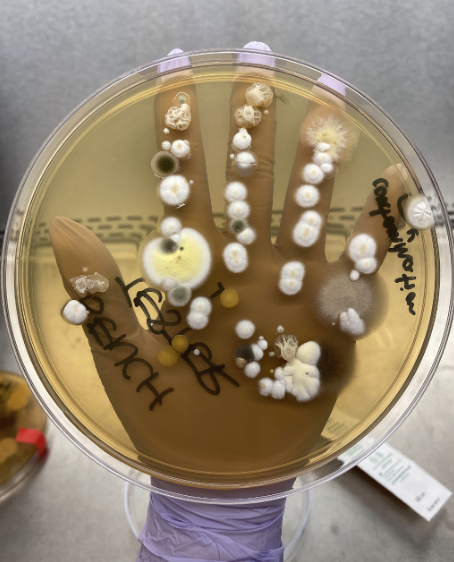
Health Science Inquiry tweet media

Health Science Inquiry
894 posts

Health Science Inquiry
@HSInquiry
An annual peer-reviewed publication for medical students and graduate students in the Health, Social, & Medical Sciences to discuss, discover & inquire 🔬
Canada Katılım Ağustos 2013
521 Takip Edilen339 Takipçiler

Are you a graduate or medical student interested in getting involved in the peer review process? 🔎
No experience required!
Send your position of interest (up to 2) with your CV to healthscienceinquiry@gmail.com
Check out our website for more details!!
healthscienceinquiry.com/index.php/hsi/…

English

We are so excited to share with you the hard work and long hours that have gone into Volume 14: Unraveling Complex Diseases with Multi-omics Technologies!
A huge thank you to the entire HSI team.👏 We hope you enjoy reading this year's articles!
Link🔗:
healthscienceinquiry.com/index.php/hsi/…

English

🧬 Taylor & Francis and HSI are partnering to offer graduate/medical students a unique publication opportunity in Epigenomics, fostering early academic engagement and publication experience!
🔗Learn more about the Epigenomics journal here: tandfonline.com/journals/iepi20

English

🧬 @tandfonline and HSI are partnering to offer graduate/medical students a unique publication opportunity in Epigenomics, fostering early academic engagement and publication experience!
Our top articles will be announced soon, stay tuned!

English

Have you heard? 📢 We're partnering with @tandfonline to offer graduate/medical students a unique publishing opportunity in Epigenomics! We're proud to be fostering early academic engagement and publication experience.
Find out more here 🔗 tandfonline.com/journals/iepi20

English

Call for Submissions! 🧬Explore multi-omics & complex diseases with Health Science Inquiry! Submit scholarly articles or short fiction (max 2,000 words)
Deadline: March 28, 2025Cash prizes for top submissions!
Details: healthscienceinquiry.com
Email: healthscienceinquiry@gmail.com

English

Are you a graduate or medical student interested in building your CV? Health Science Inquiry Journal is looking for students to join our team!
See our website for more details:
healthscienceinquiry.com/index.php/hsi/…


English

Ending the week on a creative note - don't miss some of the amazing #ClimateChange and #Health-themed photography and artwork in our 2021-2022 Volume 13! See these pieces and more in our new issue at the link in our bio! 🔬🎨

English
Health Science Inquiry retweetledi

Congratulations to Arboretum naturalist intern @miche_beltran on the research publication she co-authored with @lizdporter & @shoshanahjacobs about nature-based learning for better health in the current issue of @HSInquiry!
Check it out on page 98! healthscienceinquiry.com/ind.../hsi/iss…
@uofg

English

A highlight of our 2021-2022 issue was collaborating with @DalEpidemiology @DCpdme for the Fear Memorial Conference on #PlanetaryHealth & the #ClimateCrisis! Read our feature on the conference in our newly published issue on #ClimateChange & #Health at the link in our bio! 🌎⚕️

English

HSI writer @kat_nolan07 presented her article in the 3-Minute Elevator Pitch Competition at the #DalFearClimateChangeConference2022 and won People's Choice! 👏🏼 Read her full article now in our recently published issue on #ClimateChange and #Health at the link in our bio!

English
Health Science Inquiry retweetledi
Health Science Inquiry retweetledi
Health Science Inquiry retweetledi

Small commentary piece out today in @HSInquiry!
We discuss the impacts of climate change in the northern Ontario indigenous communities.
Link: healthscienceinquiry.com/index.php/hsi/…

English






